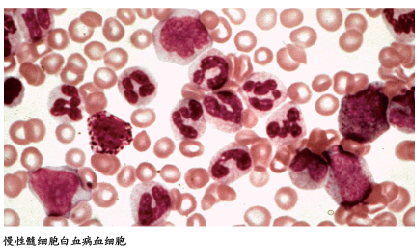

药物治疗
一线治疗选择
随着许多国家批准尼洛替尼、达沙替尼作为慢性髓细胞白血病(CML)一线治疗药物,临床医生在酪氨酸激酶抑制剂(TKI)选择上面临着诸多困惑。
澳大利亚Hughes教授认为,CML患者应根据初诊时确定的治疗目的选择TKI。对于合并其他脏器疾病的老年患者而言,CML治疗的主要目标是降低进展风险、延长生存期;对于一般情况和TKI耐受性都较差的老年患者,维持较高的生活质量远比延长生存期更重要。对于年轻患者而言,最大限度延长生存期仍是治疗的主要目标,但停药后长期缓解也是需要考虑的目标之一。此外,初诊患者的治疗还需考虑三个问题。
☆评估伊马替尼、尼洛替尼和达沙替尼临床应用的优、缺点;另外值得注意的是,尽管最佳治疗剂量仍未确定,但迄今为止数据显示伊马替尼疗效优于其他TKI。
☆对于高危患者(评分系统包括Sokal、Hasford以及EUTOS等),应选择尼洛替尼或达沙替尼。
☆或可作为一线治疗的其他方法包括博舒替尼、普纳替尼、长效干扰素(IFN-α)联合TKI等。
近年来,多种生物学标志物可用来预测TKI疗效,如IC50、OCT-1、CIP2A、GIF-1以及BIM多态性等。其中BIM缺失、OCT-1也是CML的潜在治疗靶点。这些标志物预示着今后CML研究的两个新方向:(1)如何将这些标志物与Sokal、Hasford及EUTOS等评分系统结合,建立更理想的CML预后评分系统;(2)如何将TKI与其他针对BIM缺失(BH3类似物)、OCT-1(双氯酚酸)等潜在CML靶点的药物联合,以进一步提高CML患者的疗效、降低耐药发生率。
疗效监测
尽管美国国立综合癌症网络(NCCN)2013和欧洲白血病网络(ELN)2009指南推荐3、6、12、18个月作为TKI治疗后疗效评估时间点,但3个月的监测似乎更为重要。
德国学者Hanfstein等开展一项纳入1440例患者的CML-Ⅳ研究显示,TKI治疗后3个月,BCR-ABL1水平>10%的患者5年总生存(OS)率为87%;BCR-ABL1水平>1%且≤10%患者的OS率为94%;BCR-ABL1水平≤1%患者的5年OS率为97%。来自英国伦敦翰默史密斯医院的研究结果显示,282例接受TKI治疗的CML患者中,BCR-ABL1水平>9.84%的患者无进展生存(PFS)率、OS率显著低于BCR-ABL1≤9.84%的患者。
上述研究提示,3个月的分子学缓解较6个月主要细胞遗传学缓解(MCyR)和12个月时的完全细胞遗传学缓解(CCyR)能提供更理想的预后信息。
TKI停药指证
美国学者Sweet认为,Sokal积分低危患者、TKI前接受IFN-α治疗、停药前获得长时间的完全分子学缓解(CMR)、停药前长期应用伊马替尼(>60个月)及治疗3个月时获得很好的分子学缓解,是停药后低分子学复发率和长期无治疗缓解(TFR)的良好预后因素;持续、稳定的CMR是降低停药后分子学复发的前提。
尽管如此,国际尚无TKI治疗的停药标准,停用TKI治疗仍仅限于临床试验,并未成为常规策略。因此,国内学者应根据BCR-ABL1水平开展多中心、前瞻性临床注册试验探讨中国CML患者TKI停药的可行性。而对于未纳入临床试验的CML患者,TKI停药应慎之又慎。
干细胞清除
CML干细胞表型是Lin-CD34+CD38-CD90+,具有此类表型的细胞群中BCR-ABL1+的细胞与正常造血干细胞的表型极为相似、且比例相当。
美国波士顿Ahmed教授认为,尽管伊马替尼停药后患者获得TFR提示免疫机制有助于根除白血病干细胞(LSC),但LSC仍是CML患者获得CMR后复发的根源。目前,清除LSC可采取三种策略。
☆ 针对LSC的信号通路,如JAK2、PIK3/AKT/mTOR、WNT/β-catenin、BCL-2等。
☆ 免疫学方法,如IFN-α、BCR-ABL1肽疫苗等。
☆ 针对LSC微环境,如粒细胞集落刺激因子促LSC进入细胞周期、JAK2或VEGFR1抑制剂、CXCR4拮抗剂及甲状旁腺激素等。
在这方面我国与国外差距较大,应加大CML基础研究的人才和资金投入力度。
异基因造血干细胞移植
TKI时代异基因造血干细胞移植(allo-HSCT)治疗CML有了极大的变化,Ponatinib的出现使得携带T315I突变的患者无需再接受allo-HSCT治疗。
澳大利亚Hughes教授将allo-HSCT的适应证总结为三点。
☆初诊的急变期CML患者或TKI治疗过程中进展为急变期或加速期的患者,这些患者治疗后进入慢性期。
☆对二代TKI治疗无效后,采用Ponatinib治疗仍无效的患者。
☆儿童CML未获得主要细胞遗传学缓解,或尽管应用达沙替尼或伊马替尼治疗,但 6个月时BCR-ABL1水平>10%的患者。
结语
CML的一线治疗选择、疗效监测、停药、CML干细胞清除以及allo-HSCT在CML治疗中的地位一直是业内热议的话题。此外,TKI耐药以及CML患者的生活质量等亦是目前学者讨论的热点话题。总之,从基础到临床研究的进展不仅巩固了TKI作为CML一线治疗的地位,而且其与LSC根除策略的联合极有可能迎来药物治愈CML的新时代。
第八届中国医师协会血液科医师论坛会议通知
经中国医师协会批准,中国医师协会血液科医师分会定于2014年5月8-10日在广东省广州市举行第八届中国医师协会血液科医师论坛。会议由中国医师协会血液科医师分会主办,由中山大学附属第一医院和北京大学血液病研究所联合承办。
本次论坛在秉承历届论坛特色基础上增加创新性内容。盛邀国内多位院士、著名学者等就科研方法学、转化医学等问题做专题演讲,继续以病例讨论方式提供各级医生之间近距离的专业交流,新设立了“辩论与争鸣专题”,就血液病诊治问题进行实战环节的辩论及争鸣。论坛分为3个专题:(1)重大科学技术与方法学;(2)专科医师培训——疑难病例讨论;(3)辩论与争鸣。此会议为中国医师协会一类学术会议,将授予国家级继续教育学分6分。
相信本次会议会对血液科医师提升职业素质、丰硕职业生涯产生重要影响,欢迎广大临床一线的血液科医师莅会!
报到时间:2014年5月8日全天
会议时间:2014年5月9-10日
会议地点:广州东方宾馆
大会主席:黄晓军教授 北京大学人民医院
执行主席:李娟教授 中山大学附属第一医院
大会秘书长: 刘开彦教授 北京大学人民医院
刘代红教授 北京大学人民医院
胡亮钉教授 解放军307医院
联系人:陈月 宋超
联系方式:010-88324577 Email:bayou919@sina.com








